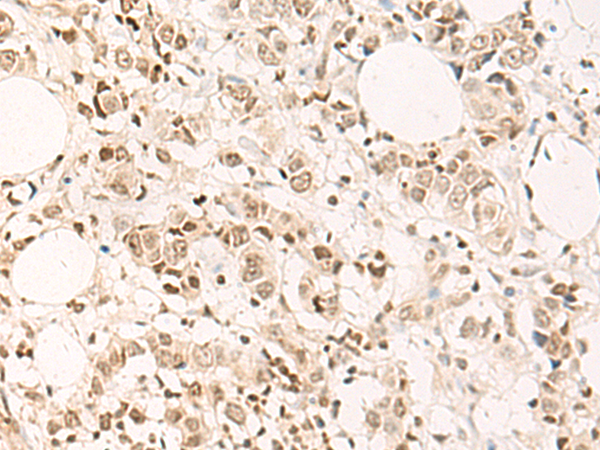

中文名稱: 兔抗DPPA4多克隆抗體
|
Background: |
This gene encodes a nuclear factor that is involved in the maintenance of pluripotency in stem cells and essential for embryogenesis. The encoded protein has a scaffold-attachment factor A/B, acinus and PIAS (SAP) domain that binds DNA and is thought to modify chromatin. Mice with a homozygous knockout of the orthologous gene die during late embryonic development or within hours after birth. Knockout embryos are normal in size at embryonic day 18.5 but exhibit skeletal and lung tissue abnormalities. This gene, when mutated, is highly expressed in embryonal carcinomas, pluripotent germ cell tumors, and other cancers and is thought to play an important role in tumor progression. Multiple pseudogenes of this gene have been identified. Alternative splicing results in multiple transcript variants. |
|
Applications: |
ELISA, IHC |
|
Name of antibody: |
DPPA4 |
|
Immunogen: |
Synthetic peptide of human DPPA4 |
|
Full name: |
developmental pluripotency associated 4 |
|
Synonyms: |
2410091M23Rik |
|
SwissProt: |
Q7L190 |
|
ELISA Recommended dilution: |
5000-10000 |
|
IHC positive control: |
Human breast cancer and Human esophagus cancer |
|
IHC Recommend dilution: |
40-200 |

購物車
購物車 幫助
幫助
 021-54845833/15800441009
021-54845833/15800441009
